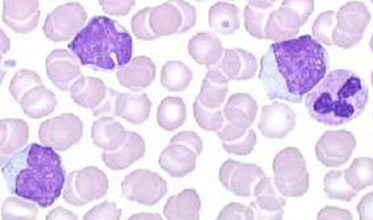
cytologia

Les Data Challenges en santé
Une approche innovante et participative qui favorise l'émergence et le partage de solutions inédites en santé.
Qu’est-ce qu’un Data Challenge ?
Les Data Challenges sont des compétitions en science des données qui visent à répondre à des problématiques médicales précises à l’aide de l’analyse des données mises à disposition.
Il s’agit plus précisément de résoudre, en un temps imparti, une problématique spécifique de data science grâce à des solutions d’apprentissage automatique. Ces compétitions se déroulent en ligne et sont généralement des problèmes de prédiction, de régression ou de classification, préalablement formulés sur la base de larges jeux de données et mis à disposition des compétiteurs.
En s’inscrivant dans une démarche d’intelligence collective et d’ouverture de la science, l’idée pour les organisateurs et les compétiteurs est de mettre leurs forces en commun afin d’accéder, à l’état de l’art de la problématique scientifique, statistique ou technique posée.
L’origine de l’initiative Data Challenges en santé
Dans le cadre du plan France 2030, le Gouvernement a lancé la stratégie d’accélération « Santé Numérique » visant à préparer l’avenir et faire de la France un leader en santé numérique. C’est dans ce contexte que la Délégation ministérielle au Numérique en Santé, le Secrétariat général pour l’investissement, chargé de France 2030, et la Plateforme des données de santé ont lancé l’initiative Data Challenges en santé.
Ainsi, depuis 2020, par le biais des appels à projets “Data Challenges en santé”, la Plateforme des données de santé accompagne des acteurs de l'écosystème de la santé dans l’organisation de compétitions portant sur des thématiques médicales d’intérêt. Ces projets bénéficient d’un soutien financier de Bpifrance ainsi que d’un accompagnement logistique, technique et organisationnel par les équipes de la PDS.
Les chiffres clés du programme
Lancée en 2020, l’initiative Data Challenges en santé stimule la recherche collaborative autour de l’IA et des données de santé. De nombreux résultats concrets ont déjà émergé de cette initiative, avec de belles perspectives à venir :
- 7 compétitions internationales organisées réunissant plus de 2000 équipes du monde entier.
- 7 nouvelles compétitions prévues d’ici fin 2026, pour continuer à faire progresser la recherche en santé.
- 21 ressources ouvertes (bases de données, modèles d’IA) mises à disposition de la communauté.
- Plus d’une vingtaine de partenaires : sociétés savantes, établissements de santé, instituts hospitalo-universitaires…
- Des centaines de téléchargements chaque mois de ces ressources.
- Des travaux d’intégration des modèles d’IA dans la pratique clinique.
Découvrez et participez aux compétitions Data Challenges en santé
Les Data Challenges en santé sont des compétitions ouvertes à tous et d’envergure internationale. Aucun prérequis n’est nécessaire, l’inscription et la participation sont gratuites.
Pour ne rien rater, vous pouvez vous inscrire à notre newsletter pour être informé du lancement de nos Data Challenges.
Le Data Challenge en cours
Les Data Challenges à venir

RESPRED_UC (Hôpital Foch)
Urologie : réponse à l’immunothérapie pour le cancer urothélial de la vessie

ML-KIDCAR (IHU ICAN)
Cardiologie, Néphrologie : prédiction d’insuffisance rénale aiguë après une chirurgie cardiaque
Retour sur les Data Challenges finalisés

ANNITIA (IHU ICAN)
Hépatologie : prédiction du risque de progression d’une stéatose hépatique non alcoolique

D-IA-GNO-DENT (CHRU Strasbourg)
ORL : détection précoce des maladies rares à composante dentaire, orale et faciale
Les bonne pratiques pour organiser un Data Challenge en Santé
L’organisation d’un Data Challenge en santé requiert des étapes de cadrages scientifique, méthodologique, financier et règlementaire spécifiques à la réutilisation de données de santé.
Pour mener un projet de ce type de façon conforme, en particulier sur le plan réglementaire, et obtenir des résultats robustes, il est important de s’informer sur les bonnes pratiques à suivre en amont de l’organisation d’un Data Challenge en santé.
Découvrez le MOOC “Organiser un Data Challenge en santé” pour vous former sur ces bonnes pratiques.
Retrouvez également tous les éléments de bonnes pratiques en téléchargeant notre Kit Data Challenge.